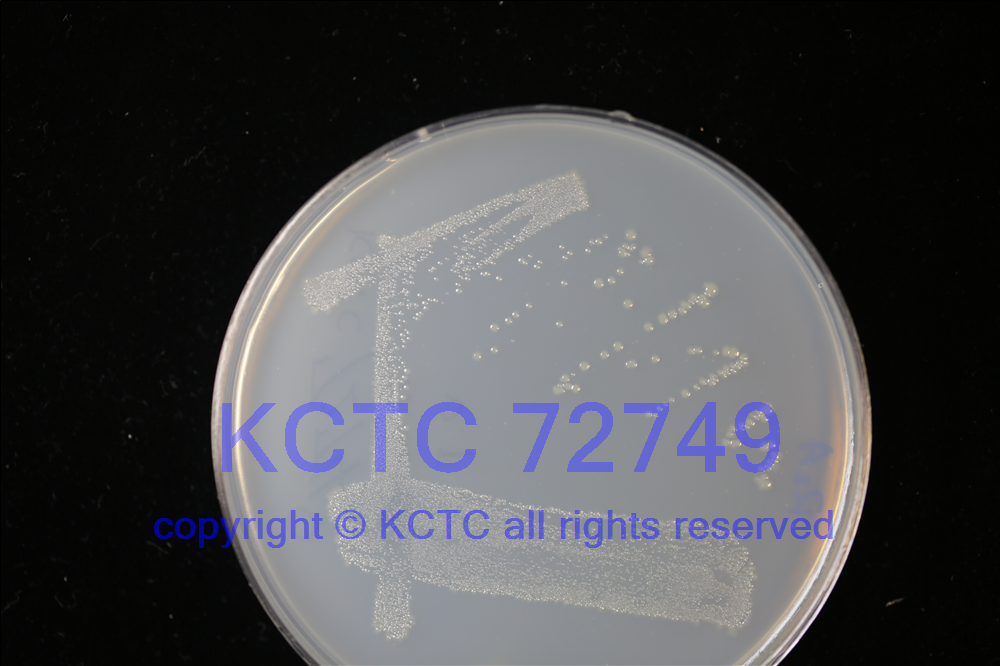

KCTC No. 72749
(KCTC Other No.)
Resource Type Bacteria
Name Dechloromonas aquae
Type Strain Yes
Biosafty Level 1
LMO No
Synonym
Phylum (ex Phylum) Pseudomonadota (Proteobacteria - Betaproteobacteria)
Genome Information
History <- Yaqi Liu, Institute of hydrobiology, Chinese Academy of Sciences
Source From freshwater aquaculture pond, China (N 3636' E 11758')
Other Collection No. ZY10, MCCC [1K08699]
Reference http://dx.doi.org/10.1007/s00284-025-04142-z
KCTC Media No. KCTC media No. 493 R2A agar medium
Oxygen Requirement Aerobic
Temperature 28 ℃
pH 7.0
Incubation Time 24-36 h [???? ???? ????? ??, ?? ? ????? ??? ?? ?? ? ??]